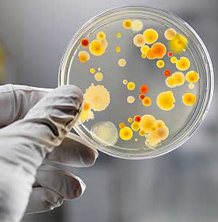

Quando se trata de produtos químicos, confie na melhor revendedora do país. Trabalhando sempre de forma profissional e prática, há 20 anos, escolha a melhor e mais segura. Escolha a Hexágono Química.

Fundada oficialmente em 27/10/1993, a Hexágono Química tem como atividade principal a comercialização de Reagentes para uso em laboratórios de controle químico de qualidade. Em permanente mudança gerada pelo crescimento de seus negócios, a Hexágono Química faz uma opção permanente pela qualidade, distribuindo produtos de 1ª linha de reagentes, e mantendo em seu quadro profissionais de alto nível que recebem treinamento permanente, com o objetivo maior de fazer de seus clientes parceiros permanentes e fiéis.
Por ser construída em seus principais profissionais, por pessoas oriundas do mercado químico, não sente quaisquer dificuldades na manutenção e extensão da cultura de reagentes frente aos clientes que lhes forem confiados.
Por favor, não hesite em nos contatar pelos links acima, ou abaixo: estamos prontos para atender qualquer dúvida ou pedido! Tenha certeza de que, ao escolher a Hexágono Química, não estará fazendo apenas uma boa escolha. Estará fazendo a melhor.
Solventes de suma importância para qualquer teste químico.
Leia Mais
Materiais e meios de cultura preparados e de qualidade para seus serviços.
Leia Mais
Produtos voltados diretamente para os testes e trabalhos químicos que você precisa.
Leia Mais
Encontre reagentes específicos para suas necessidades.
Leia Mais
Agende-se e confira os eventos que est�o por vir!!
Leia Mais
Para vidros, pap�is, assist�ncia, materiais de laborat�rio e afins, clique abaixo!
Clique Aqui!